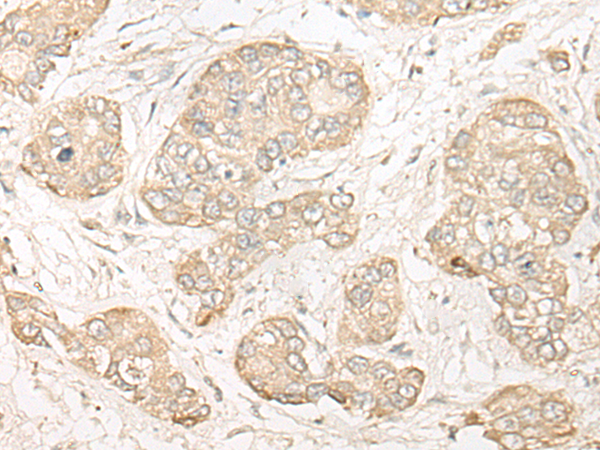

中文名稱(chēng):兔抗COMT多克隆抗體
|
Background: |
Catechol-O-methyltransferase catalyzes the transfer of a methyl group from S-adenosylmethionine to catecholamines, including the neurotransmitters dopamine, epinephrine, and norepinephrine. This O-methylation results in one of the major degradative pathways of the catecholamine transmitters. In addition to its role in the metabolism of endogenous substances, COMT is important in the metabolism of catechol drugs used in the treatment of hypertension, asthma, and Parkinson disease. COMT is found in two forms in tissues, a soluble form (S-COMT) and a membrane-bound form (MB-COMT). The differences between S-COMT and MB-COMT reside within the N-termini. Several transcript variants are formed through the use of alternative translation initiation sites and promoters. |
|
Applications: |
ELISA, WB, IHC |
|
Name of antibody: |
COMT |
|
Immunogen: |
Fusion protein of human COMT |
|
Full name: |
catechol-O-methyltransferase |
|
Synonyms: |
HEL-S-98n |
|
SwissProt: |
P21964 |
|
ELISA Recommended dilution: |
5000-10000 |
|
IHC positive control: |
Human liver cancer and Human ovarian cancer |
|
IHC Recommend dilution: |
25-100 |
|
WB Predicted band size: |
30 kDa |
|
WB Positive control: |
Hela cell lysate |
|
WB Recommended dilution: |
500-2000 |

購(gòu)物車(chē)
購(gòu)物車(chē) 幫助
幫助
 021-54845833/15800441009
021-54845833/15800441009
